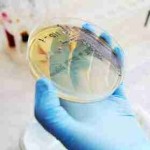

Vizualizaţi acum şi valorificaţi toate oportunităţile!
Ştiri de calitate și informaţii de afaceri pentru piaţa de construcţii, instalaţii, tâmplărie şi domeniile conexe. Articolele publicate includ:
- Ştiri de actualitate, legislaţie, informaţii statistice, tendinţe şi analize tematice;
- Informaţii despre noi investiţii, lucrări, licitaţii şi şantiere;
- Declaraţii şi comentarii ale principalilor factori de decizie /formatori de opinie;
- Sinteza unor studii de piaţă realizate de către organizaţii abilitate;
- Date despre noile produse şi tehnologii lansate pe piaţă.
Ştiri de calitate și informaţii de afaceri pentru piaţa de construcţii, instalaţii, tâmplărie şi domeniile conexe. Articolele publicate includ:
- Ştiri de actualitate, legislaţie, informaţii statistice, tendinţe şi analize tematice;
- Informaţii despre noi investiţii, lucrări, licitaţii şi şantiere;
- Declaraţii şi comentarii ale principalilor factori de decizie /formatori de opinie;
- Sinteza unor studii de piaţă realizate de către organizaţii abilitate;
- Date despre noile produse şi tehnologii lansate pe piaţă.